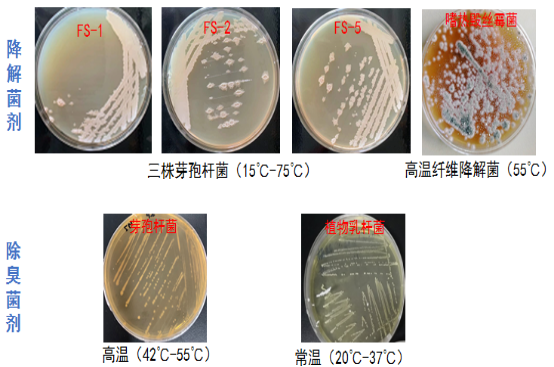

本項目擬解決目前市場上廚余垃圾分散式、小型化設備好氧堆肥處理模式過程中的技術難點,即存在減量化、無害化效率低,特別是異味重,以及資源化產品不合格等問題,開發適用于社區廚余垃圾處理的高溫微生物減量化、無害化和資源化技術。
隨著2019年7月上海垃圾分類工作的全面開展,2020年北京市出臺《北京市生活垃圾管理條例》,到2020年底,全國46個重點城市要基本建成生活垃圾分類處理系統,全國294個地級及以上城市也開始全面部署生活垃圾分類(2019年6月《關于在全國地級及以上城市開展生活垃圾分類工作的通知》),各種垃圾分類政策的出臺,使廚余垃圾治理需求加速釋放,供需缺口較大,市場需求旺盛。以地級及以上城市平均每天產生約27萬噸廚余垃圾測算,廚余垃圾總投資額市場空間為1915億;2025年廚余垃圾運營處理市場的空間預計可達146億元,市場空間廣闊。同時餐廚垃圾的資源化處理,符合國家節能環保政策。